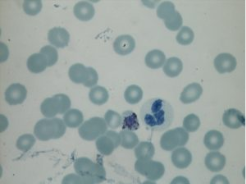

World Malaria Day is observed each year on April 25th, highlighting the efforts required to control and eventually eliminate malaria. The 2026 theme; “Now We Can. Now We Must” serves as a time to recognize progress made in saving lives and to address the persistent challenges that prevent a malaria-free world.
Malaria is a life-threatening parasitic disease, known to be spread to humans through the bites of infected female anopheles’ mosquitos. Though the tools to prevent and cure malaria exist, there is a need for sustained funding, research, and community action to eradicate malaria globally.
To mark the date, we are offering a glimpse into the LSHTM archives, spotlighting a few of the stories involved in malaria history, understanding, and ongoing development. So, buckle up as we venture into the story of one of the oldest and deadliest infectious diseases.
The Mosquito Box:

Though on first appearance you may see nothing but an old wooden box that could have been found in a grandparents attic, this nifty piece of tech is actually a Mosquito transportation box designed by Dr Louis Westerna Sambon in 1900, used to transport malaria-infected mosquitos from Rome to London. The box would originally have contained four gauze cylinders (one in each of the square compartments) for mosquito storage; only one of these remains.
The pesky little insects, once safely transported to England, were used by Sir Patrick Manson (founder of LSHTM) in his 1900 malaria experiments. His research subjects, including his son, were bitten by infected mosquitoes and developed malaria. They were quickly treated with quinine and recovered from malaria. The outcome of the experiment demonstrated to the world the mosquito-malaria theory.
Blood Slides:

Sir Ronald Ross is credited with proving mosquitoes as a vector for the spread of malaria, research for which he was awarded the Nobel Prize for Physiology or Medicine, becoming the first Briton to achieve such, in 1902. This ‘discovery’ wasn’t borne from nowhere; Ross conducted meticulous work on malaria transmission including observing malarial blood samples under the microscope to learn more about the disease. This elegant wooden box is home to many of his historic slide collection dating back to the 1890’s, which has been preserved by the LSHTM Archives Service.
In 2015, the archive team worked with experts (staff from the Public Health England Malaria Reference Laboratory and LSHTM Diagnostic Parasitology Laboratory) to re-examine the slides under a microscope. While staining techniques for slides – for example the use of gentian violet – has changed considerably since the 19th century, the slides were remarkably still viable with oocysts and gametocytes visible. The results were photographed under the microscope by Cheryl Whitehorn.

The Miss Simpson Mosquito Hood:

With mosquitos established as the transmitter of malaria, early 20th century scientific attitudes shifted to the prevention and treatment of malaria. One such area of interest was protection of the human body from mosquitos, operating on the simple philosophy that in order to transmit malaria infected mosquitos needed to bite the potential patient. And so came the rise of the ‘physical barrier’; mosquito nets, curtains and hats which blocked access to the body. Though likely not the only woman to involve herself in designing such barriers, Lady Mary Simpson is notable for her persistence.
Lady Mary Simpson invented her ‘Mosquito Hood’ which she claimed could provide protection for those working in tropical climes. The hood was designed to be lightweight, ‘comfortable to sleep in’ and easily ‘turned back’ for smoking or shooting. She promoted the use of the hood during the war, urging Ross to advocate for her to the War Office and sending samples of the hood to the British Army, as well as writing widely about the design and its advantages.


As far as we know, Simpson didn’t have much success with the hood. However, her determination and persistence, especially at a time in which women’s ideas were valued less than men’s, highlight the effort and advocacy of many less recognised individuals in the history of malaria research.
Leeson’s Expeditions

It may come as no surprise given Manson’s transport of them from Italy, that the cold and rainy environment of Britain isn’t ideal for mosquitos. Anopheles’, thrive in warm temperatures above 20 degrees Celsius (68 F) and humid environments most often found in tropical regions across Africa and Papua New Guinea. In 2024, the WHO African Region was home to 95% of malaria cases (265 million) and 95% (579 000) of malaria deaths.


In 1936, Major HS Leeson, an entomologist working at the school, set off on an expedition to study malarial mosquitoes in East Africa. The archive holds a wide collection of materials for this expedition including images in which Leeson identified mosquito hotspots and worked with his team of researchers on location control to reduce the mosquito population. The collection also offers insight into the lives of local populations. As the Archive Service continues to recognise the colonial background of our collections, it is an ongoing project to review the Leeson collection in light of our Decolonising Principles . An example of this are explored in our blog post on the short film ‘Roads To Africa’ which Leeson made during his expedition (available here ).

